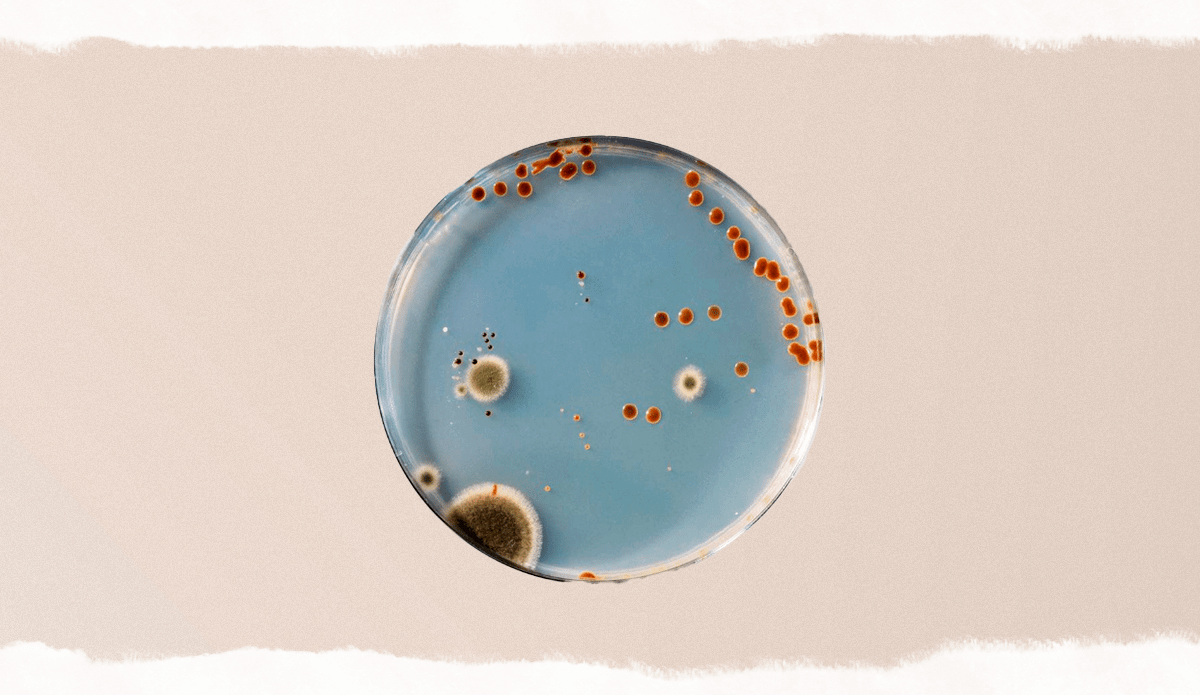

Но если она возникает регулярно, не стоит закрывать на это глаза. Нередко боль в животе является признаком серьезных проблем, которые нужно решить. Вот на что она может указывать.
1. Эндометриоз
Эндометриоз — это заболевание, при котором ткань, похожая на слизистую оболочку матки, разрастается за ее пределами.
Указывать на эту проблему может боль в животе, которая возникает во время секса в позах с глубоким проникновением, а также после него.
Бывает нелегко отличить эндометриоз от проблем с желудочно-кишечным трактом. Важно обратиться к гинекологу, чтобы исключить это серьезное заболевание или вовремя получить лечение.
2. Сухость влагалища
Сухость вагинальной ткани может появиться во время перименопаузы и менопаузы, когда уровень эстрогена в организме падает. Из-за этого секс становится неприятным и болезненным.
Последствием интимной близости при сухости влагалища может быть зуд, жжение и кровянистые выделения, а также боль в животе.
Чтобы избежать таких неприятностей, нужно использовать смазку — она поможет увлажнить сухие ткани и сделать секс более комфортным.
3. Фибромы
Фибромы — это доброкачественные новообразования на слизистой оболочке матки. Из-за них менструации становятся обильными и болезненными, а также возникает ощущение тяжести внизу живота вне зависимости от фазы цикла. Но они также могут приводить к боли в пояснице, области таза или животе во время и после секса.
Лечение фибром зависит от их размера и симптомов. Доктор может назначить гормональные препараты, но в случае, если они крупные и приносят значительный дискомфорт, их удаляют хирургическим путем.
4. Кисты яичников
Кисты, то есть заполненные жидкостью «мешочки», образующиеся на яичниках, обычно безвредны. Однако они могут вызывать периодические боли в животе, которые возникают на одной стороне тела.
Но в некоторых случаях киста может лопнуть и вызвать сильную боль и внутреннее кровотечение. Так что не стоит относиться к этой проблеме несерьезно, особенно если болезненность во время или после секса становится хронической.
5. Инфекции
Вагинальные инфекции, а также поражение мочевыводящих путей или заболевания, передающиеся половым путем, могут стать причиной боли в области живота и таза. Она возникает как во время, так и после интимной близости.
Чаще всего инфекции сопровождаются изменением цвета, консистенции и запаха выделений из влагалища.
Лечение инфекций и других вышеперечисленных проблем всегда медикаментозное. Они не проходят сами по себе, поэтому необходимо вовремя проконсультироваться со специалистом, чтобы избежать неприятных последствий.
7. Дисфункция тазового дна
При дисфункции мышцы тазового дна не могут расслабиться и координировать такие действия, как мочеиспускание и дефекация.
Эта проблема часто сопровождается болью в области таза, прямой кишки и поясницы. Болезненность может быть постоянной, в том числе и во время секса, или быть более ощутимой, когда ты пытаешься сходить в туалет.
Дисфункция тазового дна устраняется с помощью специальной терапии, состоящей из растяжки и координационных упражнений.
8. Воспалительные заболевания органов малого таза
Это проблема является распространенным последствием нелеченных заболеваний, передающихся половым путем, таких как гонорея или хламидиоз.
Они вызывают воспаление вокруг шейки матки, что приводит к боли во время и после полового акта. Также неприятные ощущения появляются во время мочеиспускания.
Но бывает, что боль внизу живота при воспалении органов малого таза становится хронической и «идет в комплекте» с неприятным запахом и нерегулярными менструациями.
Для устранения этой проблемы используются антибиотики, которые доктор подбирает исходя из симптоматики и других показателей твоего здоровья. Игнорирование инфекции или самолечение — это прямой путь к таким последствиям, как бесплодие, внематочная беременность или хроническая тазовая боль.
9. Вульводиния
Если тебя мучает повторяющаяся острая или саднящая боль, раздражение и жжение вокруг влагалища без какой-либо четкой причины, у тебя может быть вульводиния.
Это состояние обычно длится около трех месяцев и значительно осложняет сексуальную жизнь, так как интимная близость усиливает боль.
Пока неизвестно, что влияет на возникновение этого заболевания, но методики борьбы с ним существуют. Лучше всего работает многосторонний подход: врач может порекомендовать обезболивающие и другие медикаменты, терапию тазового дна, когнитивно-поведенческую терапию — все зависит от симптомов и целей лечения.
10. Проблемы с желудочно-кишечным трактом
Проникающий секс может ухудшать симптомы заболеваний желудочно-кишечного тракта, например вздутия живота, СРК, воспаления кишечника.
Конечно, не стоит постоянно терпеть боль, но и отказываться от интимной близости не стоит. Обратись к гастроэнтерологу, чтобы пройти обследование и выяснить, как себе помочь.
11. Вагинизм
При вагинизме мышцы влагалища могут непроизвольно напрягаться во время проникающего секса. В некоторых случаях это может привести к серьезным проблемам с интимной близостью, в том числе возникновению боли в животе и тазе во время или после нее.
Чаще всего вагинизм встречается у женщин, переживших сексуальную травму или насилие, а также у тех, кто слишком восприимчив к физической боли.
Лечение этого заболевания, как правило, включает в себя упражнения для мышц тазового дна, физиотерапию, а также консультирование у психотерапевта.